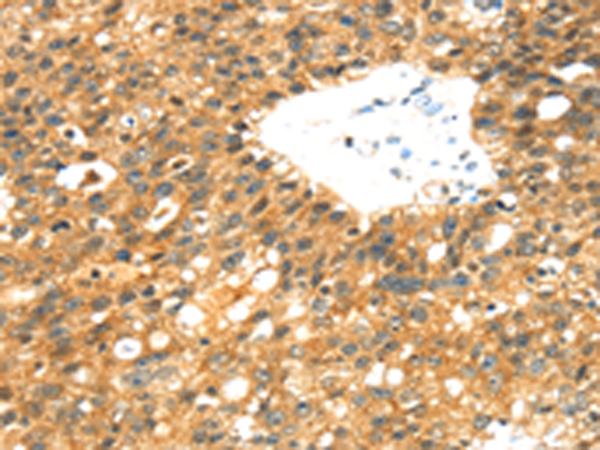
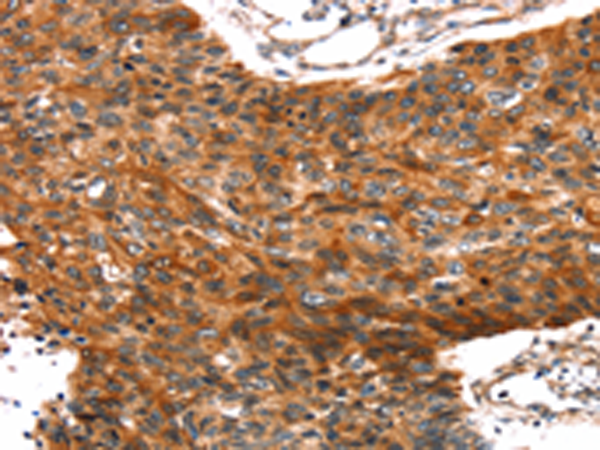

-
分类: 科研抗体货号: P08719别名: REPA2; RPA32; RP-A p32; RP-A p34应用: WB,IHC反应种属: Human
-
分类: 科研抗体货号: P08739别名:应用: WB,IHC反应种属: Human
-
分类: 科研抗体货号: P08718别名: MRB; AOVD3; ECSM4应用: IHC反应种属: Human
-
分类: 科研抗体货号: P08735别名: S100PBPR应用: WB反应种属: Human
-
分类: 科研抗体货号: P08716别名: Trif; HSD34; RNF36; HSD-34应用: IHC反应种属: Human, Mouse, Rat
-
分类: 科研抗体货号: P08734别名: MIG9应用: WB反应种属: Human
-
分类: 科研抗体货号: P08715别名:应用: WB,IHC反应种属: Human, Mouse
-
分类: 科研抗体货号: P08733别名: BCMP84; S100A15应用: IHC反应种属: Human, Mouse
-
分类: 科研抗体货号: P08714别名:应用: IHC反应种属: Human, Mouse, Rat
-
分类: 科研抗体货号: P08732别名: 2A9; PRA; 5B10; CABP; CACY应用: WB反应种属: Human, Mouse, Rat

鄂公网安备42018502007531号
鄂公网安备42018502007531号

